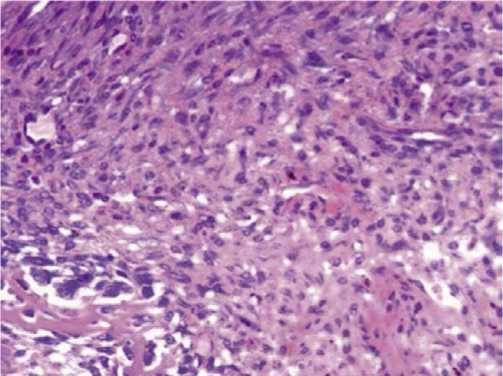

Лечение асептического некроза головки бедренной кости в эксперименте с применением криовоздействия аппликатором из пористого никелида титана
Автор: Кужеливский И.И., Гордиенко И.И., Ялунин Н.В., Немыкина Е.Н., Пономарев А.С., Черный С.П.
Журнал: Вестник Национального медико-хирургического центра им. Н.И. Пирогова @vestnik-pirogov-center
Рубрика: Оригинальные статьи
Статья в выпуске: 1 т.21, 2026 года.
Бесплатный доступ
Обоснование: проблема лечения заболеваний опорно-двигательного аппарата является одной из наиболее актуальных в современной науке. Главным фокусом для отечественной регенеративной медицины становятся способы лечения дегенеративно-дистрофических заболеваний костно-суставной системы у детей. К передовому методу регенеративной медицины относят криотехнологии. В настоящем исследовании впервые была реализована и оценена новая методика биостимулирующих операций на предложенной оригинальной модели асептического некроза головки бедренной кости. Цель: оценка эффективности субдеструктивного криовоздействия на очаг остеонекроза головки бедренной кости экспериментальной модели, максимально приближенной к болезни Легг-Кальве-Пертеса. Материалы и методы: исследование проведено на 24 кроликах породы «шиншилла» обоего пола. Животным проведен ряд оперативных вмешательств на фоне асептического некроза головки бедренной кости по туннелизации и криовоздействию аппликатором из пористого никелида титана на очаг остеонекроза для оптимизации остеорепаративных процессов костной ткани. Контрольную группу составили 8 животных, которым оперативные вмешательства не проводились. Результаты: согласно данным гистоморфологических исследований выявлен активно протекающий процесс неоостеогенеза, что свидетельствует об эффективности криовоздействия аппликатором из пористого никелида титана для предупреждения эффекта адгезии и оптимизации остеогистогенеза в условиях экспериментальной модели асептического некроза головки бедренной кости. Заключение: результаты экспериментальных исследований позволяют применить предложенный разработанный способ криовоздействия на патологически изменённую костную ткань при лечении болезни Легг-Кальве-Пертеса у детей с целью активизации репаративной регенерации в некротически изменённой головке.
Субдеструктивное криовоздействие, криорегенерация, остеохондропатия, болезнь Легг-Кальве-Пертеса, пористый никелид титана, жидкий азот
Короткий адрес: https://sciup.org/140314183
IDR: 140314183 | DOI: 10.25881/20728255_2026_21_1_73
Сryoapplicaion in aseptic necrosis of the femoral head in an experiment
Background. The problem of treatment of diseases of the musculoskeletal system is one of the most urgent in modern science. The main focus for our regenerative medicine is the treatment of degenerative-dystrophic diseases of the musculoskeletal system in children. This study examined the effects of liquid nitrogen vapor on osteogenesis in the rabbit femur. Cryotweezers made of porous nickel titanium alloy (nitinol or NiTi) obtained by self-propagating high temperature synthesis were used in this experiment. Aims. Evaluation of the effectiveness of subdestructive cryotherapy on the focus of osteonecrosis of the femoral head in an experimental model as close as possible to Legg-Calve-Perthes Disease and enhance osteogenesis in rabbit bones through cryotherapy using porous NiTi cryotweezers. Materials and methods. The study was conducted on 24 rabbits. The animals underwent of a surgical interventions against the background of aseptic necrosis of the femoral head by tunneling and cryotherapy with an applicator made of porous titanium nickelide on the osteonecrosis site to optimize osteoreparative processes of bone tissue. The control group consisted of 8 animals that did not undergo surgery. Results. It was found that a 3 s exposure time stimulates osteogenesis, which was manifested in a greater number of osteoblasts in the regenerate compared to the control sample without liquid nitrogen. It was observed that increasing the exposure to 6, 9 or 12 s had a destructive effect, to varying degrees. The most severe damage was exerted by a 12 s exposure, which resulted in the formation of osteonecrosis areas. In the samples exposed to 6 and 9 s of cryotherapy, destruction of the cytoplasm of osteocytes and osteoclasts was observed. Conclusions. The NiTi alloy produced through the SHS method offers a novel approach to the manufacture and use of cryoinstruments due to its high heat capacity and ductility, which provide rapid local cooling and its ability to prevent sticking to moist mucous tissues. The experimental results obtained make it possible to apply the proposed developed cryotherapy method to pathologically altered bone tissue.
Текст научной статьи Лечение асептического некроза головки бедренной кости в эксперименте с применением криовоздействия аппликатором из пористого никелида титана
Обоснование
Проблема лечения заболеваний опорно-двигательного аппарата является одной из наиболее актуальных в современной науке. Главным фокусом для отечественной регенеративной медицины становятся способы лечения дегенеративно-дистрофических заболеваний костно-суставной системы у детей [1–3]. Нарушение опороспособ-ности при заболеваниях крупных суставов влечет за собой нарушение социальной адаптации и снижение качества жизни. Многие исследования имеют профилактическую направленность, они нацелены на предупреждение развития заболевания либо его осложнений. Ряд работ посвящен апробированию способов регенеративной медицины в экспериментальных условиях с дальнейшим применением разработанных методик лечения дегенеративнодистрофических заболеваний костно-суставной системы у детей в условиях стационара [3; 4]. К передовому методу регенеративной медицины относят криотехнологии [1; 4; 5]. Как правило, воздействие ультранизкой температуры на биологическую ткань в современной хирургии ассоциируется с её последующим разрушением [1]. Однако при условии постепенного отведения тепла или кратковременной экспозиции хладагента существует возможность использования другого свойства ультранизких температур – эффекта субдеструктивного криовоздействия с последующей регенерацией ткани. Идея использования

субдеструктивного криовоздействия в рассматриваемом случае сфокусирована на лечении асептического некроза головки бедренной кости у детей (болезнь Легг-Кальве-Пертеса) путём туннелизации шейки бедренной кости с последующим криовоздействием на очаг остеонекроза в головке. Сплавы NiTi часто используются для изготовления криохирургических инструментов, в основном из-за их высокой биосовместимости и коррозионной стойкости [8]. Физическо-механические свойства сплавов на основе никелида титана делают его перспективным материалом для применения в криохирургии. Охлаждение NiTi до температуры жидкого азота не приводит к изменению его физико-механических свойств, в отличие от керамических или полимерных материалов. Ещё одна особенность сплавов н на основе NiTi заключается в том, что он не прилипает к поражённым тканям во время процедуры, поэтому нет необходимости нагревать инструмент, чтобы безопасно отделить его от ткани. Принцип работы аппликатора на основе никелида титана базируется на капиллярном эффекте, суть этого явления заключается в том, пористая структура удерживает жидкость за счёт капиллярных сил. Экспериментально установлено, что оптимальный размер пор составляет 90–120 мкм. Жидкий азот удерживается внутри аппликатора и постепенно испаряется, образуя пар, который используется в криотерапии. Таким образом, криотерапия происходит за счёт воздействия паров жидкого азота, которые поглощаются пористой структурой криопинцета NiTi и соприкасаются с тканью, охлаждённой до ~196 °C, что приводит к мгновенному отводу тепла от поверхности ткани [9]. Перед применением предлагаемого способа в клинике, как известно, необходимо осуществление экспериментальных испытаний на лабораторных животных.
Цель
Оценка эффективности субдеструктивного криовоздействия на очаг остеонекроза головки бедренной кости экспериментальной модели, максимально приближенной к болезни Легг-Кальве-Пертеса.
Методы
Дизайн исследования
Было проведено одномоментное интервенционное (экспериментальное), одноцентровое (поперечное) исследование.
Критерии соответствия
Исследование было проведено на кроликах породы «шиншилла» обоего пола, начиная с четырёхмесячного возраста, массой тела 2700–3500 грамм, после изоляции в карантинном отделении в течение 15 суток. Животных содержали в клетках в виварии, 12 часов день, 12 часов ночь. Питание стандартное в условиях вивария. Операции проводились под общей анестезией в соответствии с этическими требованиями к экспериментальной работе.
Условия проведения
Экспериментальные исследования проводились на базе лаборатории биологических моделей ФГБОУ ВО СибГМУ Минздрава России (заведующий лабораторией В.В. Иванов). Гистологические исследования осуществлялись на базе кафедры патологической анатомии ГБОУ ВПО СибГМУ Минздрава России (заведующая проф. М.В. Завьялова) и на базе лаборатории электронной микроскопии (руководитель А.А. Миллер). Рентгенологические исследования осуществлялись на базе отделения ветеринарии (ветеринарный врач В.И. Максимов) ветеринарной клиники при сельскохозяйственной академии г. Томска (заведующий А.П. Недзельский).
Продолжительность исследования
Планируется 10 дневное наблюдение, с последующим иссечением сформировавшегося регенерата в области туннеля проксимального отдела бедренной кости.
Описание медицинского вмешательства
Животным после экспериментального выявления наиболее оптимальной криорегенеративной экспозиции хладагента [6] проведен ряд оперативных вмешательств на фоне АНГБК по туннелизации и криовоздействию на очаг остеонекроза для оптимизации остеорепаративных процессов костной ткани. В условиях операционной под общей анестезией 0,5 мл рометара выбрито операционное поле. После внутривенного введения 0,2 мл калипсола проведен прямой разрез шкуры животного в проекции большого вертела правой бедренной кости длинной до 4 см. После разреза шкуры осуществлён доступ к большому вертелу бедренной кости. Далее произведена туннелизация шейки бедренной кости с использованием электрической дрели и сверла диаметром 3 мм. После доступа к большому вертелу и осуществления туннели-зации в отверстие помещен проводник хладагента с наконечником-кондуктором из пористого никелида титана для предупреждения эффекта адгезии в ходе криовоздействия [7]. Наконечник имеет внутренний шаг резьбы 1,5 мм и навинчивается на универсальный медицинский криохирургический аппарат «Ледок». Проведено криохирургическое воздействие в субдеструктивной дозировке хладагента в количестве 3 сек. На третьей секунде субдеструктивного криовоздействия рана наполнилась паром от хладагента. Проводник удален из туннеля. Наличие пара от хладагента явилось дополнительным критерием достаточного субдеструктивного отведения тепла, поскольку совпало с требуемой экспозицией хладагента. После криовоздействия проведен контроль гемостаза в ране. Визуально в наружном отверстии тоннеля отмечается кровяной сгусток. Остановка кровотечения и появление кровяного сгустка объясняют гемостатическое свойство ультранизких температур [8]. Рана ушита послойно. Шов обработан антисептиком. Внутримышечно поставлен антибиотик (цефурабол) 0,3 мг однократно. Все оперированные животные из наркоза вышли без

Кужеливский И.И., Гордиенко И.И., Ялунин Н.В. и др.
ЛЕЧЕНИЕ АСЕПТИЧЕСКОГО НЕКРОЗА ГОЛОВКИ БЕДРЕННОЙ КОСТИ В ЭКСПЕРИМЕНТЕ С ПРИМЕНЕНИЕМ КРИОВОЗДЕЙСТВИЯ АППЛИКАТОРОМ ИЗ ПОРИСТОГО НИКЕЛИДА ТИТАНА
осложнений, отпаивание и уход стандартный для послеоперационного животного. На 10-е сутки проведен забор регенерата у животных с проведенной туннелизацией и у животных, которым туннелизация была дополнена субдеструктивным криовоздействием. Всем животным проведено рентгенологическое исследование тазобедренных суставов в прямой проекции. В послеоперационном периоде самочувствие животных было удовлетворительным. Раза зажила вторичным натяжением. Животным группы сравнения проведены аналогичные оперативные вмешательства без криовоздействия на туннель в шейке бедренной кости.
Методы регистрации исходов
Гистоморфологические исследования (электронная и световая микроскопия) проводились без выведения животных из эксперимента в различные сроки после операции с целью изучения активности регенеративных изменений костной структуры участка некроза головки бедренной кости, полученного в эксперименте, после тун-нелизации с криовоздействием и без такового. Поскольку результаты статистической обработки результатов гистологических исследований специфичны и актуальны для узких специалистов-морфологов и гистологов, авторы сочли целесообразным привести экспериментальный пример двух животных – основной группы и группы сравнения.
Этическая экспертиза
Все эксперименты проведены с учетом требований Хельсинской Декларации обращения с животными и в строгом соответствии с Международными этическими и научными стандартами качества планирования и проведения исследований на животных и ТПК 125-2008* (02040). Экспериментальные исследования выполнены с соблюдением требований приказа Минздрава СССР № 176 от 12.08.1977 г. Этическим комитетом ФГБОУ ВО СибГМУ Минздрава России проведение научно-исследовательской работы по протоколу «Хирургическое лечение диспластических заболеваний у детей с использованием криотехнологий, имплантов никелида титана и методов ранней артропластики» (экспериментальная часть) было одобрено с заключением о соответствии запланированных экспериментальных исследований этическим нормам и регламентирующим правилам (регистрационный № 4669/1 от 21.03.2016 г.).
Результаты
Объекты (участники) исследования
Исследование было проведено на 24 кроликах породы «шиншилла» обоего пола. Животным после экспериментального выявления наиболее оптимальной криорегенеративной экспозиции хладагента [6] проведен ряд оперативных вмешательств на фоне АНГБК по тун-нелизации и криовоздействию на очаг остеонекроза для

Рис. 1. Обзорная рентгенография тазобедренных суставов экспериментального животного на десятые сутки после хирургического лечения путём криовоздействия 3 секунды.
оптимизации остеорепаративных процессов костной ткани у животных группы № 1 (основная, n = 8) и тунне-лизация без криовоздействия у 8 животных группы №2 (сравнения, n = 8). Группу № 3 (контрольную) составило 8 животных с АНГБК, им оперативные вмешательства не проводились.
Основные результаты исследования
На 10-е сутки после проведенных оперативных вмешательств интраоперационно под наркозом был иссечен сформировавшийся регенерат в области туннеля проксимального отдела бедренной кости. Визуально определялись светлые плотно-эластичные белесоватые наслоения, внешне напоминающие соединительную ткань. Перед иссечением криорегенерата животному было проведена обзорная рентгенография тазобедренных суставов (Рис. 1).
Однако в условиях эксперимента на животных малых размеров рентгенографические методы исследования малоинформативны и низкодоказуемы, поэтому наиболее предпочтительными являются микроскопические способы доказательства эффективности предложенной методики. Далее проведен забор криорегенерата с использованием глазного скальпеля Optimum и микроложечки фолькмана из области туннеля шейки бедренной кости для проведения морфологических исследований (световая и электронная микроскопия). Помимо забора криорегенерата был произведен забор материала из туннеля шейки бедренной кости животных группы сравнения, не подвергшихся дополнительному криовоздействию. Гистоморфологическое исследование регенерата группы сравнения демонстрирует обычное образование первичной костной мозоли через развитие хрящевой и соединительной ткани. Далее представлены микроскопические исследования зоны криорегенерата в условиях модели АНГБК. Наиболее информативная

Рис. 2. Криорегенерат из туннеля после трехсекундного криовоздействия. Полутонкий срез. Окраска – толуидиновый синий. Увеличение х60.
Рис. 3. Выраженная пролиферация остеобластов, фибробластов, васкуляризация и инфильтрация единичными лимфоцитами в образце ткани после туннелизации подвергшейся криовоздействию на протяжении 3 секунд на фоне остеонекроза.
картина неоостеогенеза, демонстрирующая активную кальцификацию регенерата и типичные признаки активного неоостеогенеза, представлена на 60 кратном и электронном микроскопическом увеличении. Световая микроскопия криорегенерата при 60-кратном увеличении с трёхсекундной экспозицией хладагента демонстрирует интенсивную кальцинацию регенерата в условиях АНГБК. Микроскопическая картина схожа с трёхсекундной экспозицией на фоне патологически не изменённой кости. Первичная костная мозоль состоит из волокнистой и ретикулофиброзной ткани. Регенерат представлен цепочками остеобластов (Рис. 2).
Микроскопически на увеличении 400 выявлена выраженная пролиферация остеобластов и фибробластов, васкуляризация с формированием мелких сосудов капиллярного типа, а также инфильтрация единичными лимфоцитами (Рис. 3).
При исследовании электронных микроскопических снимков на увеличении 2500 выявлено, что остеокласты характеризуются большим количеством включений в цитоплазме, что характеризует активную резорбцию костной ткани. Отмечается наличие значительного количества остеобластов с цитоплазмой, богатой органеллами. Это свидетельствует о наличии активных процессов остеосинтеза, что является типичным для репарации костной ткани (Рис. 4).
При исследовании электронных микроскопических снимков на увеличении 4500 так же выявлены активные процессы регенерации. Остеобласты в большом количестве. Их цитоплазма содержит значительное количество органелл, что свидетельствует о высокой синтетической активности. Остеоциты имеют неотличимое от нормального строение. Межклеточное вещество характеризуется наличием большого количества коллагеновых волокон. Определяется активное обызвествление костного матрикса (Рис. 5).

Рис. 4. Туннелизация с криовоздействием 3 сек. Остеокласт (стрелка) с включениями в цитоплазме. Остеобласт. Электронная микрофотография. Увеличение х2500.

Рис. 5. Туннелизация с криовоздействием 3 секунды. Остеобласт (стрелка) с цитоплазмой, богатой органеллами. Увеличение х4500.

Кужеливский И.И., Гордиенко И.И., Ялунин Н.В. и др.
ЛЕЧЕНИЕ АСЕПТИЧЕСКОГО НЕКРОЗА ГОЛОВКИ БЕДРЕННОЙ КОСТИ В ЭКСПЕРИМЕНТЕ С ПРИМЕНЕНИЕМ КРИОВОЗДЕЙСТВИЯ АППЛИКАТОРОМ ИЗ ПОРИСТОГО НИКЕЛИДА ТИТАНА
Обсуждение
Результаты гистоморфологических исследований при различном увеличении (световая, электронная микроскопия) показали активно протекающий процесс неоостеогенеза, что свидетельствует об эффективности методики 3-х секундной экспозиции хладагента для оптимизации остеогистогенеза в условиях экспериментальной модели АНГБК.
Резюме основного результата исследования
Было обнаружено, что воздействие в течение 3 с стимулирует остеогенез, что проявляется в большем количестве остеобластов в регенерирующем участке по сравнению с контрольным образцом без воздействия жидкого азота. Было замечено, что увеличение продолжительности воздействия до 6, 9 или 12 с в разной степени оказывает разрушительное воздействие. Наиболее серьёзные повреждения были вызваны воздействием в течение 12 с, что привело к образованию остеонекроза участков. В образцах, подвергшихся криотерапии в течение 6 и 9 с, наблюдалось разрушение цитоплазмы остеоцитов и остеокластов.
Обсуждение основного результата исследования
Благодаря технологическому прогрессу малоинвазивные операции стали альтернативой классическим хирургическим процедурам, позволяющим решить ряд медицинских проблем. Например, криодеструкция или криоабляция – это один из методов криохирургии, который используется для удаления опухолей путем воздействия на ткани экстремально низких температур [12]. Металлы и сплавы являются классическими материалами для криоинструментов [8]. Аналогично в нашем исследовании мы использовали в качестве аппликатора сплав на основе никелина титана. Существует множество работ, демонстрирующих успешное лечение различных заболеваний с помощью хладагентов в криохирургии [11; 12]. Например, в работе [10] была проведена криохирургическая операция по удалению остеосаркомы в колене у ребёнка с последующей реконструкцией. Авторы исследования сообщили об отсутствии осложнений после операции и достижении хороших функциональных результатов. Криодеструкция также применяется для лечения злокачественных и доброкачественных опухолей печени, предстательной железы, почек, молочной железы, кожи и костей [10]. Аналогичным образом наша разработка может быть внедрена в практический клинический опыт, в частности для лечения остеохондропатии головки бедренной кости.
Заключение
Проведённые экспериментальные исследования обосновывают эффективность применения аппликатора из пористого никелида титана для предупреждения адгезии ткани и доказывают выраженный регенеративный эффект субдеструктивного криовоздействия на патологически измененную костную ткань с предложенной экспозицией 3 сек. Разработанная пористая структура аппликатора состоит из мелких и крупных пор, которые позволяют удерживать хладагент (жидкий азот) внутри инструмента, обеспечивая криотерапию за счёт воздействия паров жидкого азота при его испарении Полученные результаты экспериментальных исследований позволяют применить предложенный разработанный способ криовоздействия на патологически изменённую костную ткань при лечении асептического некроза головки бедренной кости у детей путём туннелизации шейки бедренной кости до патологически измененных очагов костной ткани и субдеструктивного криовоздействия с целью активизации репаративной регенерации в некротически изменённой головке.
Источник финансирования . Экспериментальные исследования на лабораторных животных было поддержано Российским научным фондом, грант № 19-72-10105.


